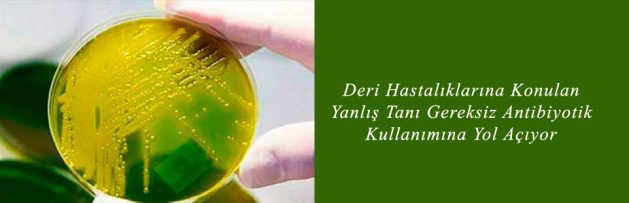

Deri Hastalıklarına Yanlış Tanı Konulması Gereksiz Antibiyotik Kullanımına Yol Açıyor
![]()
4 Kasım 2016
JAMA Dermatology’nin 2 Kasım 2016 sayısında yayımlanan araştırmaya göre, deri hastalıkları olan hastalara yanlış konulan selülit tanısı gereksiz antibiyotik kullanımına ve hastane yatışına neden oluyor.
Boston’daki Brigham and Women’s Hospital’dan araştırmacıların yaptıkları araştırmaya göre selülit tanısı konan hastaların üçte birinde aslında selülit yok.
Araştırmacıların 30 aylık bir dönemde acil serviste hastane yatışı olan, ekstremite selüliti tanılı 259 hastanın sağlık kayıtlarını inceleyerek elde ettikleri sonuca göre, selüliti olmayan 79 hastaya selülit tanısı konmuştu. Hastaların yüzde 85’inde hastane yatışı ihtiyacı bulunmuyordu, yüzde 92’sindeyse antibiyotik kullanımı gereksizdi.
Elde edilen bulgulara göre deri hastalıklarına yanlış tanı konulması yılda 130 000 gereksiz hastane yatışına neden oluyor. Bu da yıllık 515 milyon dolar harcamaya yol açıyor. Gereksiz antibiyotik kullanımı ve hastane yatışı muhtemelen binlerce ölümcül infeksiyona da yol açıyor. Brigham and Women’s Hospital Dermatoloji Kliniği Yatan Hastan Konsültasyon Direktörü Arash Mostaghimi hastane yatışından önce dermatoloji kliniğiyle konsültasyonun yanlış tanıyı azaltabileceğini vurguluyor.
Bakteriyel bir hastalık olan selülit yaralanma, yanık, ameliyat gibi durumlarda A grubu streptokok bakterilerinin dokularda oluşturduğu deri infeksiyonlarını ifade etmekte kullanılıyor. Belirtileri arasında ateş ve titreme, lenf düğümlerinin şişmesi, deride kızarıklık ve acıma sayılıyor.
Haberin Tam Metni için [Tıklayınız]
JAMA Dermatology’de Yayımlanan 2 Kasım 2016 Tarihli Makale için [Tıklayınız]